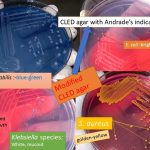
CLED agar/medium

Tag: CLED agar: introduction
CLED Medium: Introduction, Uses,Composition, Preparation, Colony Characteristics, Modification and Limitations
 Introduction of CLED Medium CLED stands for cysteine, lactose, and...
Introduction of CLED Medium CLED stands for cysteine, lactose, and...
CLED Agar: Introduction, Uses,Composition, Preparation, Colony Characteristics, Modification and Limitations
Introduction of CLED Agar CLED stands for cysteine, lactose and...
Introduction of CLED Agar CLED stands for cysteine, lactose and...
